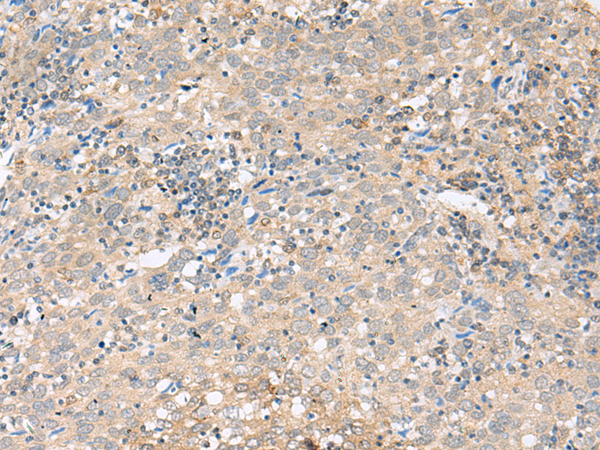

-
分类: 科研抗体货号: P13389别名: NSE2; FAM84B; BCMP101应用: WB,IHC反应种属: Human
-
分类: 科研抗体货号: P13372别名: MCVD; MLAT4; LEPREL1应用: IHC反应种属: Human, Mouse, Rat
-
分类: 科研抗体货号: P13377别名: FVL; PCCF; THPH2; RPRGL1应用: IHC反应种属: Human, Mouse, Rat
-
分类: 科研抗体货号: P13388别名: NSE1; FAM84A; PP11517应用: WB,IHC反应种属: Human, Mouse
-
分类: 科研抗体货号: P13371别名: p18; PDRO; C11orf59; p27RF-Rho; Ragulator1应用: IHC反应种属: Human, Mouse, Rat
-
分类: 科研抗体货号: P13376别名: NRAC; C14orf77应用: IHC反应种属: Human
-
分类: 科研抗体货号: P13387别名: 9F; XAP5; HXC26; HXC-26; DXS9928E应用: WB,IHC反应种属: Human, Mouse
-
分类: 科研抗体货号: P13370别名: Kcn1; Kv1.8应用: IHC反应种属: Human, Mouse
-
分类: 科研抗体货号: P13405别名: EPP; FCE应用: WB,IHC反应种属: Human, Mouse
-
分类: 科研抗体货号: P13386别名: DA3; DA5; MWKS; DAIPT; FAM38B; HsT748; HsT771; FAM38B2; C18orf30; C18orf58应用: IHC反应种属: Human, Mouse

鄂公网安备42018502007531号
鄂公网安备42018502007531号

